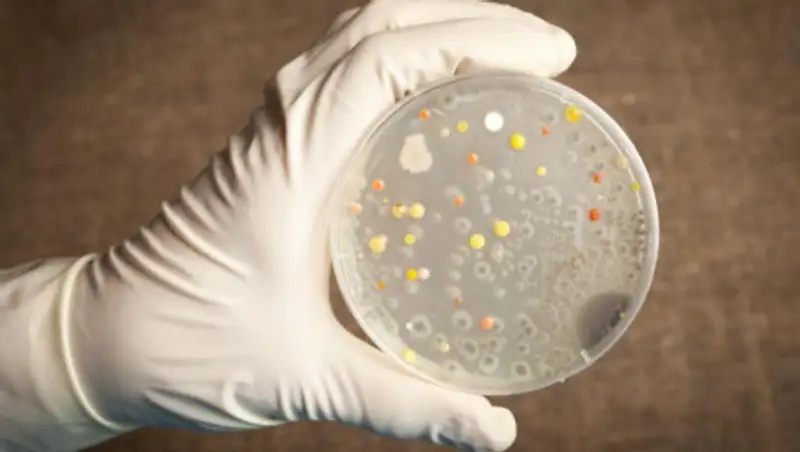
Сообщения о сибирской язве в Казахстане являются фейком - МСХ

На микробной карте нью-йоркского метро нашли ДНК бактерий чумы и сибирской язвы
 Zakon.kz
Zakon.kz
Общие результаты исследования внушают оптимизм: большой угрозы заразиться (или необходимости носить защитные перчатки) ученые не обнаружили.
Американские ученые 18 месяцев проводили анализ ДНК с различных станций нью-йоркского метро и составили PathoMap — карты всех микроорганизмов подземки. Исследователи обнаружили более 15 типов живых существ, причем 48 процентам ДНК не удалось найти известного хозяина. На центральных станциях обнаружились следы сибирской язвы и бубонной чумы, сообщается в журнале ЖЖЖ. Коротко об исследовании сообщается в пресс-релизе, передает Лента.ру.
Доктор Крис Мэйсон (Chris Mason) и его коллеги брали мазки с турникетов, билетных киосков, поручней, перил, скамеек, урн и других поверхностей всех станций крупнейшей системы подземного транспорта в мире. В итоге они собрали более десяти миллиардов единиц анализа, которые обработал суперкомпьютер.
Общие результаты исследования внушают оптимизм: большой угрозы заразиться (или необходимости носить защитные перчатки) ученые не обнаружили. Большинство из 637 известных бактерий, вирусов, грибов и животных, чьи ДНК присутствуют в подземке, не являются патогенами — это безвредные обитатели организма человека (кожи и пищеварительного тракта прежде всего).
Однако 12 процентов бактерий оказались связанными с болезнью. На 27 процентах поверхностей нашли живые антибиотикорезистентные микробы. Также ученые обнаружили две пробы с фрагменты ДНК Bacillus anthracis (возбудителя сибирской язвы) и три — с плазмидами Yersinia pestis (возбудителя бубонной чумы). Впрочем, эксперименты показали, что это ДНК исключительно мертвых бактерий.
«Хотя мы и нашли следы патогенных микробов, их концентрация слишком мала, чтобы угрожать здоровью человека. Более того, отсутствие известных случаев заражения опасными заболеваниями в Нью-Йорке на фоне наличия их возбудителей являет собой яркое свидетельство силы иммунной системы нашего тела, его способности беспрестанно адаптироваться к окружающей среде», — заявил Мэйсон.
Ученых удивило, что примерно половина (48,6 процента) собранных последовательностей ДНК не удалось опознать по основным базам данных США — видимо, они принадлежат неизвестным организмам.
Наконец, лишь 0,2 процента образцов связаны с геномом человека — хотя ученые работали с зонами, где ежедневно проходит до 6 миллионов людей. С помощью инструментов AncestryMapper и ADMIXTURE исследователи попытались воссоздать демографическую картину станций. Оказалось, что их карта соответствует данным переписи населения. Например, в населенном китайцами районе около Чайнатауна (на Манхэттене) обнаружилась смесь генов, характерных для обитателей восточной Азии и Латинской Америки. «Теоретически наш метод позволит полиции выявлять этническое происхождение горожан, побывавших на станции», — отметил Мэйсон.
Распространенность бактерии Pseudomonas stutzeri
Изображение: Mason / Cell Systems
Поделитесь новостью
Читайте также
Если вы видите данное сообщение, значит возникли проблемы с работой системы комментариев. Возможно у вас отключен JavaScript